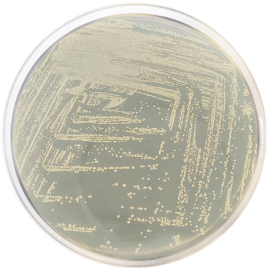
main product photo

Close
DEXTROSE AGAR 500 grams/bottle
SKU
CDL/1021
Brand
CONDALAB
Pre-order (Deliver in 8 to 12 weeks)
Dextrose Agar is a medium suitable to cultivate a wide variety of microorganisms, with or without blood added. The high dextrose concentration yields abundant growth in less time than other media and shortens lag period of older cultures. Although is a medium for general use, it is not appropriate for haemolyses studies due to the high content of dextrose.
The Peptone mixture and Beef extract provide provide nitrogen, vitamins, minerals and amino acids essential for growth.
Dextrose is the fermentable carbohydrate, providing carbon and energy. Sodium chloride supplies essential electrolytes for transport and osmotic balance. Bacteriological agar is the solidifying agent.
Dextrose Agar is a medium suitable to cultivate a wide variety of microorganisms, with or without blood added. The high dextrose concentration yields abundant growth in less time than other media and shortens lag period of older cultures. Although is a medium for general use, it is not appropriate for haemolyses studies due to the high content of dextrose.
The Peptone mixture and Beef extract provide provide nitrogen, vitamins, minerals and amino acids essential for growth.
Dextrose is the fermentable carbohydrate, providing carbon and energy. Sodium chloride supplies essential electrolytes for transport and osmotic balance. Bacteriological agar is the solidifying agent.
| Brand | CONDALAB |
|---|
Write Your Own Review

Validate your login